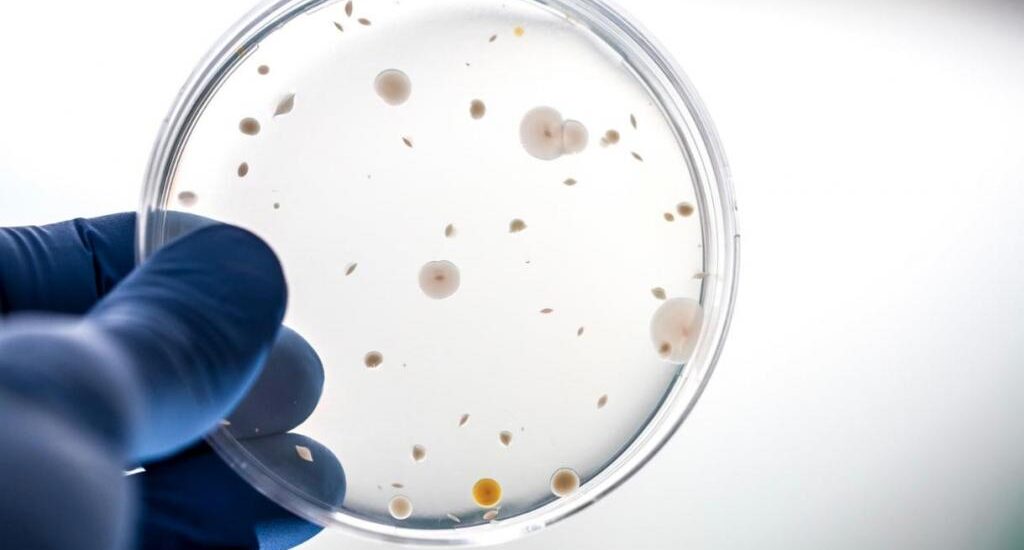
Clostridium Diagnostics Industry

The Global Clostridium Diagnostics Industry is on the brink of an impressive growth trajectory, poised to expand at a CAGR of 12.2% from 2022 to 2032, increasing its market value from US$2.5 billion to an estimated US$7.8 billion. This remarkable projection follows the market’s substantial growth, which recorded a CAGR of 13.6% between 2015 and 2021.
The escalating growth of the Clostridium Diagnostics Industry can be attributed to several factors. Notably, a surge in awareness-raising initiatives focused on clostridium-related illnesses, combined with a rise in their prevalence, has paved the way for this robust market expansion.
One key development driving this growth is the increasing emphasis on the development and availability of vaccines against clostridium-related diseases. In March 2022, Japan took a significant stride in this direction, allocating a budget of US$1.6 billion to support vaccine and drug projects as part of a broader strategy to combat infectious diseases. This ambitious endeavor, overseen by SCARDA, will establish a flagship R&D site dedicated to fostering innovative collaborations and managing funds for pivotal R&D projects.
Request a Sample Copy of the Report Now.
https://www.futuremarketinsights.com/reports/sample/rep-gb-15203
The launch of new vaccines in the market is another vital factor driving the market during the forecast period. For instance, in August 2021, Huvepharma Canada Corporation Inc. launched a new vaccine that has been shown to be effective against necrotic enteritis (NE) due to Clostridium perfringens type A in broiler chickens.
In addition, emerging companies such as, Acurx Pharmaceuticals, Cubist Pharmaceuticals, Endo Aesthetics, Avisa Pharma, and MGB Bio Pharma are expected to make a significant contribution in developing the market during the forecast period. However, lack of awareness and scarcity of resources in developing countries are expected to hamper the market growth during the forecast period. Also, the high costs involved in R&D and vaccine manufacturing are expected to be other factors hindering the market growth in the assessment period.
However, growing partnerships among players are projected to counter the hampering factors and boost the market. For instance, in March 2021, Peggy Lillis Foundation for Clostridium difficile infections announced a partnership with Ferring Pharmaceutical through a new sponsorship to assist new and existing patient advocacy initiatives.
Methodology Details Just a Click Away!
https://www.futuremarketinsights.com/request-report-methodology/rep-gb-15203
Key Takeaways from the Market Study:
- The immunoassays technology is expected to dominate the global clostridium diagnostics market at a CAGR of 11.6% during 2022-2032
- The clostridium diagnostics Industry in the U.S is anticipated to display a CAGR of 11.8% during the forecast period
- The U.K clostridium diagnostics Industry is predicted to hold a market value worth US$ 330 Million by 2032
- The Japanese clostridium diagnostics Industry is estimated at a CAGR of 11.1% during the forecast period.
“Growing launch of new vaccines by various players of the market along with the increasing popularity of awareness campaigns as a useful tool for market growth is expected to play a significant role in driving the market during the forecast period,” says an FMI analyst.
Competition Analysis
- Abbott Laboratories
- F. Hoffmann La-Roche AG
- Siemens AG
- Becton, Dickinson & Company
- Beckman Coulter Inc.
- Sysmex India Pvt. Ltd.
- Thermo Fisher Scientific Inc.
- Fujirebio US Inc.
- BioMerieux S.A
- Diazyme Laboratories Inc.
Access Exclusive Market Insights – Purchase Now!
https://www.futuremarketinsights.com/checkout/15203
Key Segments Profiled In The Global Clostridium Diagnostics Industry
Clostridium Diagnostics Industry by Technology:
- Immunoassays-based Clostridium Diagnostics
- Molecular Clostridium Diagnostics
Clostridium Diagnostics Industry by End User:
- Clostridium Diagnostics in Hospitals
- Clostridium Diagnostics in Government Diagnostics Laboratories
- Clostridium Diagnostics in Independent Laboratories
Clostridium Diagnostics Industry by Product:
- Clostridium Difficile Diagnostics
- Clostridium Perfringens Diagnostics
- Clostridium Botulinum Diagnostics
- Clostridium Tetani Diagnostics
- Clostridium Sordell Diagnostics
Author
Sabyasachi Ghosh (Associate Vice President at Future Market Insights, Inc.) holds over 12 years of experience in the Healthcare, Medical Devices, and Pharmaceutical industries. His curious and analytical nature helped him shape his career as a researcher.
Identifying key challenges faced by clients and devising robust, hypothesis-based solutions to empower them with strategic decision-making capabilities come naturally to him. His primary expertise lies in areas such as Market Entry and Expansion Strategy, Feasibility Studies, Competitive Intelligence, and Strategic Transformation.
Holding a degree in Microbiology, Sabyasachi has authored numerous publications and has been cited in journals, including The Journal of mHealth, ITN Online, and Spinal Surgery News.
About Future Market Insights (FMI)
Future Market Insights, Inc. (ESOMAR certified, recipient of the Stevie Award, and a member of the Greater New York Chamber of Commerce) offers profound insights into the driving factors that are boosting demand in the market. FMI stands as the leading global provider of market intelligence, advisory services, consulting, and events for the Packaging, Food and Beverage, Consumer Technology, Healthcare, Industrial, and Chemicals markets. With a vast team of over 5,000 analysts worldwide, FMI provides global, regional, and local expertise on diverse domains and industry trends across more than 110 countries.
Contact Us:
Future Market Insights Inc.
Christiana Corporate, 200 Continental Drive,
Suite 401, Newark, Delaware – 19713, USA
T: +1-845-579-5705
For Sales Enquiries: sales@futuremarketinsights.com
Website: https://www.futuremarketinsights.com
LinkedIn| Twitter| Blogs | YouTube